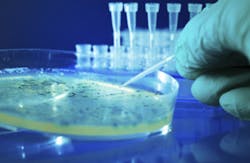
luchschen/Essentials/iStock luchschen/Essentials/iStock

TILLAMOOK, Ore. — The Oregon Department of Environmental Quality (DEQ) has fined the Tillamook County Creamery Association $56,532 for wastewater violations, according to a press release.
The penalty was levied “because the association exceeded its wastewater discharge permit limitations for biochemical oxygen demand, total suspended solids and bacteria, specifically E. coli,” noted the release. Waste from the facility ultimately flows into the Wilson River.
DEQ also held the association responsible for creating deposits and slimy vegetation in the discharge area, stated the release. The association was warned about the deposits in 2010 and 2012.
The association has worked to improve its treatment systems, reported the release, including installing new aeration pumps. The group must either appeal or pay the penalty by June 10.
Click here to read the entire release.